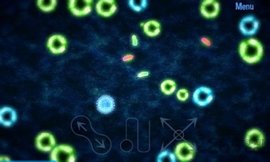
微生物模拟器中文版

游戏介绍
微生物模拟器游戏特色
1、按下屏幕以移动视角
2、两个手指滑动收缩
3、在屏幕上画一个圆圈以选择您想要控制的免疫
4、单击其中一个生物进行选择
5、当选择一个生物或一个蛋时,他点击要移动的目标
6、你可以选择一种抗炎药,然后双击你的一种生物来增加其等级。生物只有3级
7、你的目标是捕获或摧毁所有太空生物
8、然后,他选择了特定的免疫力,并点击空的生物来捕捉它们
9、他拿起免疫力,点击细胞捕捉它们
微生物模拟器游戏详情
1、这样你就能尽快了解细胞的最新变化,
2、它可以让玩家观察细胞如何在非常近的距离移动,
3、整个游戏可以让玩家学习与细胞相关的各种知识!
4、在手机的帮助下,他们可以观看各种精彩的细胞运动及其截面形状,
微生物模拟器游戏亮点
1、捕获所有敌人,增加你的微型生物的力量并改善它们
2、随着游戏的进行,你可以看到更多的微型生物。气氛很轻松!
3、有很多不同的细胞在等你[小小]游乐园
4、它可以放在水槽里,让它们醒来后尽情享受
微生物模拟器游戏描述
1、她把手机放平,按照指示左右倾斜,让手机移动;
2、激活图示后,将显示新的级别。你将挑战这些级别;
3、唤醒微博后,她可以把它放在水槽里,同时让它轻微移动;
4、你可以选择其中的一个或两个来照顾他们并训练他们;
微生物模拟器怎么玩?
1、按住屏幕以移动视角
2、两指滑动以缩放
3、在屏幕上画一个圈以选中你要控制的抗体
4、点击你的一个生物以选中
5、选中生物或抗体时,点击目的地以移动
猜你喜欢
下载地址
相关文章
- 诛仙2鬼王怎么加点 鬼王加点推荐 2025-08-20
- 诛仙2见影灵泉奇遇任务怎么做 见影灵泉奇遇任务流程攻略 2025-08-20
- 三国天下归心诸葛亮怎么样 诸葛亮技能介绍一览 2025-08-20
- 三国天下归心追击队怎么玩 追击队玩法教学 2025-08-20
- 三国天下归心武将怎么获得 武将获取方法 2025-08-20
- 星痕共鸣剧毒蜂巢怎么获取 剧毒蜂巢获取攻略 2025-08-20
- 新三国志曹操传李儒之影怎么打 李儒之影打法教学 2025-08-20
热门游戏
热门教程
- 1
- 2
- 3
- 4
- 5
- 6
- 7
- 8
- 9
- 10